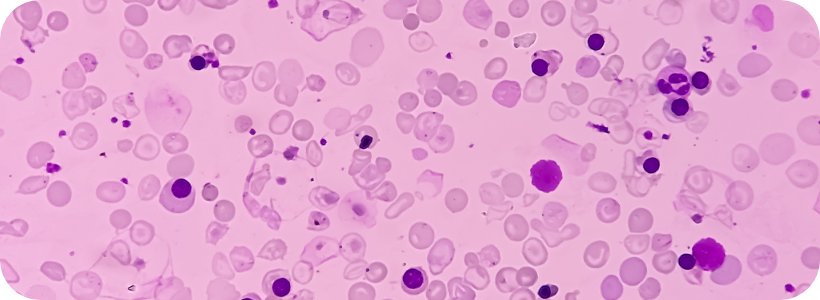

3 Tablets
BCAA Tablets







BCAA Tablets
QUALITY IS OUR STANDARD

SAME DAY
SHIPPING

BACKED BY
RESEARCH

SATISFACTION GURANTEED

EXCEPTIONAL SUPPORT
Quick Facts
- 2:1:1 Ratio Of Leucine To Isoleucine And Valine
- Maintain Muscle Anabolism (Growth And Development)
- Decrease Muscle Catabolism (Breakdown)
- Easy To Swallow Tablets
- Made In The USA
- Nothing To Risk With Our 100% Guarantee
STRAIGHT FACTS FROM OUR CUSTOMERS
What to expect
BCAAs help you achieve your goals by increasing protein synthesis and muscle growth over time. They can also prevent fatigue by assisting the released insulin in your body to fuel your tired muscles, thus allowing you to work harder during workouts.
Expect to boost protein synthesis, recover faster, and grow more muscle over time. If you don’t get enough BCAAs you can experience fatigue and slower muscle growth as BCAAs promote muscle protein synthesis. The effects of BCAAs depend on the intensity of your training and nutrition, but you should feel the effects on recovery within a few days.
BCAA supplements are not essential for everyone if you’re getting enough in the diet, however they can help maximize results and supplement the diet if you are not getting enough. They are 100% necessary on a daily basis if your dietary protein intake is below 1g per pound of bodyweight a day.

Can You Get BCAAs From Food?
Muscle building and high intensity training/nutrition programs recommend taking BCAAs. BCAAs are needed daily and can be generally consumed through a regular healthy diet. Foods that contain BCAAs are chicken, fish, eggs, dairy, lentils, red meat, soy protein, and nuts.
In order to get the recommended amount of BCAAs per day naturally from food, one would have to consume multiple servings of the above foods. As an estimate, you would likely need to spend around $100-200/week to get enough from food, depending on things like age, height, weight, gender, and activity level, etc.
Of course, these foods provide other nutrients, and you will likely eat some of these foods anyway, as you have to eat. However, many people choose to supplement so that they know they are consistently getting in enough BCAAs to maximize muscle growth, especially on training days.
Why Take BCAAs From Crazy Muscle?
We chose to have a 2:1:1 ratio of leucine, isoleucine, and valine because it’s been shown in research to be the most effective. It was shown that leucine had a better effect on protein synthesis, but they’ve also found that increased levels of leucine by itself doesn’t yield that much extra results. Taking leucine alone vs taking it with the 2:1:1 ratio with the other 2 BCAAs has been shown to have less effective results. The short answer as to why this happens is that our muscles naturally contain a 2:1:1 ratio of leucine to valine to isoleucine.
There are A LOT of supplement companies that claim that a higher BCAA ratio than 2:1:1 is far more beneficial, but this is not true. Dosing higher levels of any of these BCAAs outside of the 2:1:1 ratio will likely deplete the other two BCAAs as valine has cognitive benefits and isoleucine has fat burning benefits. Any ratio higher than this is a marketing gimmick and a complete waste of money. Our 2:1:1 ratio BCAA Tablets are formulated with a 2:1:1 ratio of leucine to isoleucine and valine. Boost your protein synthesis into overdrive and get back in the gym faster.
Here are all 3 branched chain amino acids:
Leucine (1,500 mg / serving), Isoleucine (750 mg / serving), Valine (750 mg / serving)
TYPICAL BCAA SCHEDULE
30 DAY SUPPLY





BCAA Usage
Watch the video below to find out why Three-Atine is the perfect fit for your goals.The general recommended dose if BCAAs is 20g/day of combined leucine, valine, and isoleucine. The dose should also be a 2:1:1 ratio of leucine (2-10g) and valine/isoleucine (48-72mg per kg or bodyweight) per day. To maximize the benefits of your BCAA tablets, at a minimum, take 3 tablets before your workout. For maximum results, take 3 additional tablets after your workout.
The tolerable upper limit of BCAAs is 35g/day of BCAAs, so you don’t want to consume more than this. Taking this much wouldn’t’ be effective anyway, and would be a waste of money. You don’t need to cycle BCAAs on/off, therefore you can take them every day to help maximize your results. You can also take BCAAs on an empty stomach or with food. The best time of the day to take BCAAs is around your workouts, half of the portion of the daily limit pre-workout and the other portion post-workout.
Frequently Asked Questions
1. Do You Need To Cycle BCAAs?
There's no need to cycle on/off BCAAs so feel free to take it every day.
2. Can Women Use CLA The Same Way As Men Do?
Some companies decide to market BCAAs products separately for women and men, however this is just a gimmick – BCAAs work the same for men and women. The dose should depend on a person’s total body weight, overall goals, etc. However, there is not enough reliable information about the safety of taking branched-chain amino acids if you are pregnant or breast feeding. Stay on the safe side and avoid use.
3. Are BCAA Tablets Safe To Take?
BCAA supplements have been on the market for decades, and many years of research on BCAAs has studied the effects on metabolism, neurology, physical performance, and interactions with medical condition.
BCAAs are completely safe to take, but the tolerable upper limit of BCAAs is 35g/day.
There aren’t many known side effects of taking BCAAs for the general population. However, consuming them as a supplement could interact with some medical conditions. It is always a good idea to speak with your healthcare provider before starting any supplement regimen.
Branched-chain amino acids might affect blood sugar levels, and this might interfere with blood sugar control during and after surgery. Stop using branched-chain amino acids at least 2 weeks before a scheduled surgery.








